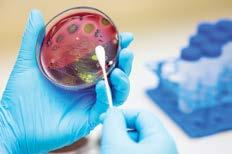

Incorporating Western Midwife




















Our highly trained ANF Industrial Officers are ready to help.
This free service is available to all ANF members for all industrial and professional matters.
We are here to help. Don’t hesitate to book a Helpline appointment through your iFolio.

The ANF and its members have a big year ahead of us. With two major EBAs ramping up, Ramsay and the Public Sector, now is a critical time in the fight for fairer pay and conditions for nurses and midwives, with a now two-year overdue agreement with Ramsay. The ANF in early-mid April ran a short-burst campaign aimed at getting Ramsay back to the negotiating table after months of avoidance. In response, while negotiations did resume, Ramsay also initiated legal action for our ads claiming the information in them was wrong, despite the ads containing information that came from their own employees. Rest assured this will not hinder the negotiation process and we will continue to be in contact with Ramsay members as we proceed.
The 2024 Public Sector EBA negotiations are also around the corner. As many of you would have seen, Public Sector Teachers were originally offered 11 percent over three years, despite their union asking for 12 percent over two years to help ease inflationary costs being felt by many. In response to the State Government’s offer the teachers conducted a half day strike, one of the largest in WA history. Now the State Government has increased the offer to 12 percent over three years, this increase while small, gives us a light at the end of the tunnel for flexible negotiations. Along with the teachers, the Police Union have also begun their new campaign for wages and conditions, with ads running across multiple mediums. It is good to see Public Sector unions fighting for well deserved pay rises and conditions, after the 2022 Public Sector EBAs in which most unions accepted 3 percent - leaving the ANF as the last union standing in the previous campaign.
With our current agreement expiring October 11 2024, we are in the process of putting together our Log of Claims which will be collated from the input of ANF public sector members. Despite the Cook Government's continued hardball stance on wages, now that the wages policy itself has changed, no longer locking wage increases at a set percentage, this gives us more flexibility in bargaining. While we cannot reveal an exact asking figure without consulting as many ANF members as possible, rest assured we are intending on taking a similar path in that we expect the next wages increase to make up for seven years of wage stagnation under the Labor Government.
The simple truth is if wages and conditions are not attractive, less people will be inclined to study or work in the profession, let alone in WA. Changes must be made, with cost-of-living skyrocketing for Western Australians, wages need to keep up, and job conditions just as much. The ANF will continue to fight on your behalf in these difficult times.







In the realm of wage campaigns, timing can be just as crucial as the demands on the table. This is particularly evident in the case of ANF members negotiating with the State Government of Western Australia, where historical patterns reveal a compelling narrative: wage negotiations held in the lead-up to a state election tend to yield more favorable outcomes for nurses and midwives than those conducted at other times.
This phenomenon is not merely coincidental but underscores the importance of interplay between political cycles and labor rights, offering valuable insights into strategic negotiation tactics.
Over the years, there have been notable instances where nurses and midwives have significantly benefited from timing their negotiations around election periods.
Specifically, the years 2001, 2005 and 2013 stand out as exemplary cases where nurses not only recovered previously lost conditions but also achieved unprecedented new ones, setting benchmarks



for nurse compensation across Australia and making WA nurses and midwives the highest paid in the country at those times and for many years following.
But what does this mean for the upcoming 2024 Public Sector EBA?
Well, it means ANF members are in a far better bargaining position this time round than we were in 2022. This history of Public Sector EBAs that fall on or before election years have resulted in more favourable pay and conditions than EBAs that do not. 2001 is not the only example, but a true testament to this.
Throughout the 90s, WA’s nurses and midwives lost a range of conditions under the ANF’s leadership at the time. 2001 proved to be a period of recovery for our professions in WA. When then first term State Secretary Mark Olson came into the role after this period of losses, 2001 was the first EBA where nursing and midwives began to claw back conditions.



The campaign began in September of 2000 in which ANF members closed 1 in 4 hospital beds, with this action leading to a 13.5 percent pay rise. After the change of government from the Liberal Court Government to Labor’s Gallop Government, there was continued resistance to the other claims and demands of ANF members, so a second campaign was launched immediately after the State Election which lasted from February to June 2001. The second phase of this campaign saw the ANF achieve an even higher 18 percent wage rise over 3 years – the highest ever, as well as:
• The return of regional Public Sector nurses into a single agreement
• Night shift penalty rate increased to 20 percent
• Return of hourly on call rate
• All nurses working over 70 hours a fortnight offered full time hours + ADOs
• All staff entitled to 10 days Public Holiday leave and pro rata for part time staff
• Paid parental leave for the first time (6 weeks)
• Permanent night staff included in definition of continuous shift worker
• Professional Development Leave introduced –2 days for metro and 4 days for rural
• Qualification allowance – one off payment
• Various rural gratuity payments to assist recruitment in difficult-to-staff areas




The 2001 EBA was indeed a time of winning for the ANF and WA’s nurses and midwives.
However, one cannot understate the importance of election years. Governments want to essentially ‘buy’ votes, and a workforce of 20,000 Public Sector nurses and midwives is a strong voting base. It may not be fair, but it’s politics. EBAs that do not line up with election years, like the most recent 2022 Public Sector EBA, faced that challenge as well as a very powerful and overrepresented McGowan Government at the time. The current Cook Government is simply a continuation of that, but this time round, their goal is to retain Government and their majority.
The Cook Government will not want to deal with potential industrial action and widespread media campaigns from both the ANF and the new Nurses and Midwives WA political party, particularly after the Cook Governments many policy blunders in not only health, but prisons and crime, housing, cost-of-living and more.
The ANF is fully prepared for another widespread media campaign, the question is: is Premier Cook ready and willing for round two?






The ANF in WA is the first of the ANF branches to offer an extended hours Helpline service, and will now be available from 8am to 8pm, Monday through Friday.
This expansion of hours is specifically designed to better accommodate the diverse schedules of our members, including those working night shifts, clinic hours and those working in theatres.
David Poole, ANF Councillor and PCH Job Representative, has been working with ANF Secretary Janet Reah to work out the hours that best suit ANF members and make the 12 hour Helpline service a reality.
David says that from the time he was elected to the ANF Council he has sought ways to modernise, improve and highlight our services to members and he feels that nothing is more critical to members than the first line of advice provided by the ANF Helpline.
“Night staff told me they would appreciate an earlier start on the Helpline so they didn’t have to wait up after their night shift and theatre staff told me it is often difficult to make an appointment in the 9am to 5pm window.”
He says the other critical feature of the Helpline service is ensuring the calls to members are made on time.
ANF Secretary Janet Reah agrees and has spent the last few months working with David and the ANF Helpline Team to develop the resources, procedures, and systems to ensure ANF members obtain most of what they need during their Helpline appointment.
Janet Reah said it’s essential ANF members are getting the correct advice from reliable sources, rather than places where information is unverified or uninformed on the most recent regulatory and industrial practices.
“It is always concerning to read advice being given on social media which is at best generic and at worst is simply incorrect and may result in a member losing entitlements or making a bad decision,” Janet said.
“I am sure many giving their opinion are well meaning but advice on industrial and professional matters needs to be specific to the workplace and the personal circumstances of the ANF member.
"And that is why I continually encourage members to make an appointment on the ANF Helpline or send the Helpline Team an email to obtain advice and information that is relevant to your workplace and your circumstances.

“We now work on the basis of getting the information and advice to members during the call. Where further research is required we have developed systems and resources to ensure a same day delivery on most occasions.”
Janet says members often call the ANF Helpline needing assistance to draft letters to their employer and those letters are supplied to the member within two working days depending on the complexity of the issue.
Janet says that where issues may take longer to resolve, they are referred to the Industrial Service Team.


“If the member requires a referral to the ANF’s free legal service, then that is also done during the initial Helpline appointment.”
David hopes that members will take full advantage of the extended hours to get the comprehensive support they deserve and obtain reliable, accurate information from the source.
“The ANF Helpline team consists of trained professionals and are better placed to help you than anyone else.”
And the best part? They are now available for 12 hours a day, 5 days a week.
Consistent Availability: We now have appointments every 15 minutes.
Reliable Support: Count on our team to call on-time and give precise advice and assistance.
Letter Writing Assistance: Not only do we provide advice, but we also help draft any necessary letters for our members.
Legal Referrals: The ANF Helpline serves as a gateway for prompt referrals to our ANF Legal Service for critical issues like allegations, AHPRA matters, the death of a patient, or crafting a statement for your employer.
Workers Compensation: Speedy referrals to our personal injury lawyers.
The ANMF Cross Border and Interstate Agreement ensures members of any ANMF branch, including those from Western Australia, remain fully covered and protected when working interstate.
Nurses and midwives, like any other professional, will get job offers or opportunities all over Australia, not just in the state they were born in.
The agreement covers all states and territories, but there are a few things all members should know when planning on working or moving interstate. This could be for a short-term offer or a permanent move.
Members should hold ANMF membership in the state or territory in which they normally work and live. If this changes members must let their current branch know as soon as possible.
If you are moving from WA to live long term in a different state or territory, then you will need to transfer your membership to the ANMF branch in that state. You can do this by contacting your current branch.
In this case “long term transfers” means any employment contracts that last for 12 weeks or more, and where work takes place on a continuous basis. So, if you live in WA and get a six-month fulltime contract in Tasmania then you will need to change your membership to Tasmania for the duration of the contract. You can always change back if you move back to your home state.
Things are a little different if your employment interstate is shorter, or if you are employed in two states at the same time.
For any employment contract less than 12 weeks, individual arrangements will be made between the state or territory where the member usually lives, and the state or territory where the member will be working.
In the first instance, members should notify the branch in the state or territory where they have primary membership to ensure arrangements can be made.
Usually, this will mean that an agreement can be made between the primary branch (where the member usually lives) and the secondary branch (where the short term job is located) to ensure the member remain protected during their brief stint interstate.
This will mean a member can remain a member of the primary branch. For professional or industrial advice or assistance members will still need to contact their primary branch in the first instance.
It is very important that all ANMF members let their primary branch know about plans to work temporarily interstate, as it allows both branches to plan how expenses for coverage, such as legal expenses, will be met.
Sometimes members will get a job interstate, without having to actually move interstate, such as working with telehealth or telenursing.
Members involved in providing nursing or midwifery remotely should be members in the state or territory in which they are employed, not in which they live.
Working remotely means that members will possibly be interacting with clients or patients outside of their membership state. If issues arise with interstate patients or clients then the branch where membership is held may need to contact the other branch for further assistance or advice, such as about legislation that applies in that state or territory. This means the member should contact their primary branch in the first instance.
Students who are employed in positions eligible for ANMF membership should apply for membership in the state or territory in which they are working for the majority of the time. Students who are not employed in positions eligible for ANMF membership should apply for membership in the state or territory in which their education provider is based.
A member working casually for short periods of time, whilst travelling around Australia, should retain membership in their primary branch. Again, members should always let their primary branch know about their plans. Travelling members who need assistance should in the first instance contact their primary branch. The primary branch will then be able to get in contact with the relevant secondary branch for assistance, and in some cases the secondary branch will take the lead on resolving the matter.
If you have a question about the ANMF Cross Border and Interstate Agreement you can always get in contact with the ANF Membership team.
Workplace meetings are a regular occurrence for all professionals, not just nurses and midwives. These meetings could be about a range of serious matters such as complaints, allegations or disciplinary action. You are entitled to procedural fairness, and the ANF is here to support you. If you are called into a formal meeting you can call the ANF for assistance.
You are entitled to a fair hearing. This means you must be provided with all the required information regarding the meeting, as well as being given reasonable time and an opportunity to respond.
The decision maker should be impartial.
For public sector workers, public sector standards apply in relation to procedural fairness for disciplinary and grievance processes.
Most private sector employers will have a documented process for dealing with complaints and investigations. This is often to protect them if their process is called into question during an unfair dismissal claim.
You should be aware of the standards and procedures at your workplace. There are some simple steps to deal with this process.
You have every right to know what the meeting is about before you attend.
You should not have to attend a meeting outside of work hours.
You do not have to attend the meeting alone. Ask a support person to attend with you.
You should be given enough notice to prepare for the meeting.
You should be advised of the process being undertaken, given a copy of the procedure if you ask for it, and be advised of the possible consequences.
This meeting is only to discuss the issue identified prior to the meeting. If other topics are raised, you can request another meeting to discuss those.
You should have access to any documents you might need to refer to, including patient notes.
If you attend on your own, you can request a support person at any stage if you become concerned.
Listen carefully and take notes. Take your time in responding. If you are hearing allegations for the first time, ask that they be put in writing, and ask for time to respond.
If you feel upset or harassed during the meeting, ask for a break or request to reschedule the meeting.

If you haven’t already, contact the ANF, particularly if allegations have been made. Remember, in most cases there will usually be some requirement for confidentiality, particularly if there is an investigation.
Nurses are often asked to sign a record of the meeting. If this is the case, you should be given the opportunity to review the document and make any changes you feel are necessary.
Having a support person attend the meeting with you can be helpful. Your support person can act as a witness and provide support by taking notes to record what is discussed, and asking for breaks if you become upset or stressed. They are not there to act as an advocate or argue on your behalf.
If you don’t know who take to a meeting, contact the ANF to discuss the circumstances.
More serious matters might involve your employer’s lawyers or even the police. If you receive a meeting request with your employer’s lawyers, please contact the ANF first to make sure you have the support you need. It may be helpful to have your own legal advice prior to attending. It is often possible to reschedule meetings until you’ve had a chance to obtain your own legal advice.
If you are called to a meeting and find the police there, remember you have the general right to remain silent and to advise them you wish to contact your ANF lawyer first. There are some questions you must answer by law, including your name, address and date of birth.
You are entitled to seek independent legal advice before being interviewed or providing a statement, and you should be aware that anything you say could be used against you at a later date. We strongly advise you to have statements checked by the ANF before submitting them. We get calls from members after they have submitted a statement or spoken to the lawyer or the police. This can impact what the ANF and our lawyers can do for you going forward.
Disclaimer: This advice is general in nature and not a substitute for specific legal advice in relation to particular circumstances.

Most, if not all, nurses and midwives will have experienced the ever-present and time consuming shadow of paperwork in health care. Some might be surprised to learn the issue is so widespread that it has a name: documentation burden.
Not all paperwork is bad, a lot of it is a vital way of recording and sharing patient data, but the sheer volume of paperwork can be overwhelming, demoralising and unnecessary. To learn more about the issue, the Western Nurse asked an expert.
Nurse Researcher at St John of God Subiaco Hospital and ANF member Dr Alannah Cooper has been researching documentation burden and developing a tool to help healthcare organisations reduce documentation burden. After the issue of documentation burden was raised at the hospital nursing and midwifery council, she chose to investigate documentation burden at St John of God, but also because the problem is so widely apparent in nursing.
“Documentation is a universal burden. It doesn’t matter which country or specialisation you are in. This is one of the reasons I was interested in researching it,” Dr Cooper said.
While the issue is well-known there was little in the way of a concrete understanding of it. There were a number of papers describing documentation burden, but there was a lack of solutions to the issue in the literature..
“Papers published on the subject focussed more on discussions around the problem,” Dr Cooper said.
Common issues with documentation burden had been captured and described in the Patients Not Paperwork report published by the NHS in the United Kingdom. This was a large survey of health professionals. There was also a qualitative study with nurses in

of the value of documentation.
Dr Cooper had heard about documentation burden directly from nurses. Her PhD focussed on nurse resilience. As part of her studies into this field she found nurses would often mention the matter of paperwork, often unprompted.
“Nurses will bring up the issue of documentation burden even when not asked, which demonstrates the scale of the issue,” Dr Copper said.
Overall, Dr Cooper was hoping to reduce time spent on documentation and increase time spent on direct patient care.
To measure the scale of the issue Dr Cooper’s team shadowed nurses and midwives at a maternity ward as they went about their work. The team would note the type of activities being undertaken and how long the activities took. This included direct patient care, communication between staff and, of course, paperwork
While the results varied slightly across shifts, in some cases as much as 30 percent of time on shift was spent on paperwork. On top of this, nurses and midwives were also frequently staying behind to complete paperwork.
This fits with Dr Cooper’s own personal and professional experience as a nurse.
“I can’t tell you how many times I stayed behind to finish paperwork. It happens all the time for nurses and they aren’t getting paid for it,” Dr Cooper said.


“It is not just paperwork either. Nurses are often staying behind to help with patients as well. There is a lot of unpaid work being done by nurses.
“Healthcare systems around the globe would grind to a halt without the unpaid time of so many nurses. This is even true of breaks which nurses regularly don’t take.”
The burden of documentation seemed to stem from two major sources, the duplication of information and overly-standardised paperwork.
Essentially, nurses were repeatedly filling out paperwork with the same information on the same patient across the system, or they were completing paperwork that required redundant information which did nothing to improve patient care.
“Duplication was a major cause of concern and frustration,” Dr Cooper said.
“So was the standardised approach to assessment, which created paperwork where it might not be needed. This blanket approach means a lot of patients were getting paperwork where previously it would have been up to the judgement of the clinician.
“This takes up time.
“The problem with a one size fits all approach is that it is simply ticking boxes where it isn’t needed. Nurses feel a lot of documentation is just to meet accreditation standards.”
To explain this, Dr Cooper used the example where a patient has come into the maternity ward to have a baby, but is not ill or injured. The same level of assessment for falls risk and pressure injuries are
“I can’t tell you how many times I stayed behind to finish paperwork. It happens all the time for nurses and they aren’t getting paid for it,”
completed for these healthy women as for acutely unwell patients and patients with chronic and complex comorbidities. These assessments may not be relevant for many maternity patients.
Part of the solution proposed by Dr Cooper would see nurses given more freedom to make decisions regarding what documentation is needed and when.
“Nurses are not saying no documentation, they are calling for good documentation. Documentation is essential for good communication between staff and organisations, but we should empower nurses and midwives to use their judgment as clinicians.”
To help organisations better measure the scale of the issue, Dr Cooper and her team developed a tool to measure nursing and midwifery documentation burden.
The Burden of Documentation for Nurses and Midwives, or BurDoNsaM, was designed to measure the burden of documentation, which in turn can help identify areas where documentation burden can be reduced to improve clinician and patient satisfaction.
The BurDoNsaM survey is published in the Journal of Advanced Nursing and has been translated into several other languages and is being used internationally.
“We drew on the literature to develop our tool and validate a measure of known issues,” Dr Cooper said.
“It is now available in Turkish and Chinese, and it is being used in the USA. It is great to be able to provide a tool anyone can use.”


The Australian Nursing Federation would like to thank the Osborne Park RSL Sub-Branch for their gracious invitation to this year’s ANZAC Day Dawn Service.
ANF State Secretary Janet Reah said it was a great privilege to lay a wreath in acknowledgement and remembrance of those nurses who supported our servicemen, served themselves or lost their lives during armed conflicts.
“I’m honoured to have been invited, and to have been given the opportunity to meet with members of the RSL and others who had served,” Ms Reah said.
“It was great to see so many people braving the morning cold, including a number of nurses and healthcare workers.”
The Dawn Service itself was very moving, with a heartfelt speech delivered by Osborne Park RSL Sub-Branch President Richard Troughton.
The march was led by members of the 10th Light Horse and their steeds, which was a great addition to the ceremony.
Thanks also has to go to the hard-working team who put on a sausage sizzle breakfast for everyone who attended. Given how many people were there it was no mean feat.










According to the Australian National War Memorial over 3,000 nurses served in the First World War, tending to injured soldiers in Europe, Africa and Asia. The services they performed as part of their duties would see countless men survive the war and return home. For those who could not be saved, often it was the nurses who would stay with them, to make sure they died in what comfort could be given and, crucially, that they did not die alone.
It is therefore a matter of great oversight that the stories of these First World War nurses have often been left in the recesses of history, overshadowed by other stories.
As the author of the recently published Great War Stories: 1914-1918 Nurses of the South West, local historian Jeffery Peirce has sought to address this oversight. His new book collates the life stories of 33 First World War nurses from the south-west of Western Australia. He started looking into their stories a few years ago, and these nurses quickly became his primary focus.
“Once I found the first nurse, I was committed to finding everyone who had been through the south west. Once I had researched two nurses my whole direction of research changed,” Mr Peirce said.
He was researching and writing a book on the Battle of Pozieres at the time. There were a few delays with this, so he thought he would check the details of a few nurses, as this was going to be his next project. As soon as he started his research into nurses, he parked the other project, and devoted his time to this.
“The nurses took me over. I’m very passionate about them,” Mr Peirce said.
“I wanted the world to know what they had done. Every major book written on Australian First World War nurses tends to make a comment that the service of our nurses in the First World War has been greatly under-acknowledged.

“Even the local archivists and local curators will tell you this is an issue. Not enough people know the extent of service of Australian nurses, and WA nurses were right up there in terms of service, and many of the ships heading overseas left from Fremantle.”
These WA nurses operated all over the globe, often under exhausting conditions. The sheer weight of the number of injured and dying soldiers was close to unimaginable, but on top of that nurses would also be dealing with a range of horrific injuries caused by the new generation of
weapons. Mr Peirce noted that despite this, the nurses showed a remarkable dedication to their patients.
“What took me with the First World War nurses, and why I have a greater appreciation for nursing in general, is how they were completely devoted to their duty.
“They didn’t take their eye off what needed to be done for their patients.

“Some of them served in casualty clearing stations, which were the closest point to the front line. They were getting men, horribly injured, straight from the battlefield.”
As part of his research Mr Peirce came across a letter from a nurse relating how at one point she had worked 24 hours straight in the surgical unit.
“The doctors were completely exhausted and said to the nurse they all needed to take a one-hour break. That was it. They went and tried to rest, but an hour later they were back in the surgical unit.
“There were four or five beds going flat out with surgeries, lots of amputations and so on. She opened the door to see what the queue was like. She said there were more than 50 men, in all states of serious injury.
This nurse had to tell these men that the doctors were going to stop operating, so they could rest, a task that must have been confronting before so many injured. She noted that not one man was groaning or complaining. This would be a recurring theme throughout her service.
“The men waited. They knew they were working on another man, and they were happy to wait. They knew there was an Aussie nurse ready to help them. That devotion to service was extreme, their sacrifice was enormous. Many people have grossly underestimated their impact on the war.”
Time and again Mr Peirce found clues to the hard conditions under which these women worked. He recounted another story where one of the 33 nurses in his book found herself as the only fully qualified nurse on a hospital transport ship.
As the only nurse she had to document every patient onboard, including their service number, and take brief notes on the nature of their injuries. All of this along with dressing their wounds.
There were 400 soldiers on the ship.
“It took her 24 hours to record all the soldiers and do the serious dressings. After that she rotated between decks to treat the soldiers. Some were on deck, and some were in the hold.”
After 24 hours she was found, completely exhausted and asleep on the upper deck.
The care these nurses gave was not just for physical injuries. They also supported injured and distressed men through times of great trauma.
“A number of men reported in letters and in conversations with their family, that they would never have got back home without the attention of the nurses. In one case a nurse recounted a soldier telling her ‘I cant wait to die’. The nurse stayed with him, and spoke to him about home, family, the countryside and gave him a vision to look forward to. This sort of thing was a regular occurrence.”
What stood out to Mr Peirce about the nurses he researched was not just their exceptional dedication to saving lives, but also a dedication to preserving life till the natural end.
“If they knew the man was going to die, they would try to stay with them. Where there were numerous men dying overnight obviously that was a heavy task.
“I think there is one line that sums it up for me: the nurses contributed noble acts of selflessness.
“That to me is the statement that covers all the nurses. It really rings true.”
These noble acts of selflessness continued after the war, with the majority of the 33 nurses remaining as nurses in peacetime. The selflessness of nurses may also, in part, explain why they did not get the recognition they deserved.
Mr Peirce said that an exchange between Australian historian C.E.W. Bean and a highly decorated matron who herself had served summed this up almost perfectly.
Following criticism that his history of the war had neglected to properly acknowledge nurses, Bean had asked the matron why she had not raised the performance of nurses on a national or international scale.
“Her response was that nurses were concerned that if they became too vocal it would take the gloss off what the men had achieved,”
Mr Peirce said.
This is certainly a worthy, and selfless, sentiment.
Jeff Peirce book Great War Stories: 1914-1918 Nurses of the South West is out now and can be purchased from his website: greatwarstories1914-1918.com/great-war-stories-nurses-of-thesouth-west/
Read this article and complete the quiz to earn 1 iFolio hour
Read this article and complete the quiz to earn 1 iFolio hour
The pelvis is a ring structure consisting of the sacrum, coccyx, and innomnate bones (pubis, ischium and ilium).1,2 The pelvic ring contains an extensive vascular system, major nerves, urogenital organs, and the rectum.1,2
The pelvis is a solid structure and great force is required to disrupt the pelvic ring.2 Pelvic fractures are high energy injuries, most commonly caused by motor vehicle crashes and collisions with pedestrians, falls from height, and crush injuries.1,3,4
Pelvic injuries range from minor to life threating, depending on the extent of the injury and the involvement of blood vessels and organs in the pelvic cavity.1,4 High energy pelvic trauma is often associated with concomitant internal injuries, such as haemorrhage, major ligament instabilities, injury to the bladder, urethra, rectum, vagina, liver, spleen or bowel, and nerve damage.1
Pelvic fractures are uncommon; only two to eight percent of fractures involve the pelvis. 4 However, pelvic fractures are associtated with high morbidity and mortality; overall mortality is 10-30% and up to 50% if associated with shock.3,4 All pelvic fractures have the potential to become life-treatening.2,5
Pelvic trauma includes pelvic ring disruptions, and acetabular and avulsion fractures. 1
Pelvic ring disruptions
A pelvic ring disruption results from fractures in two or more places.6 They are classified according to their location and stability. 4
There are various systems for classifiying pelvic fractures, including the Young-Burgess classification.7 The Young-Burgess classification considers the direction of the forces (lateral, anteroposterior, and vertical) and the intensity of the force and/or severity of the injury (graded from I to III).1,4
Lateral compression fractures are caused by a lateral force being applied to the pelvis, leading the hemipelvis on the side of the injury to rotate inwards.4 Lateral compression fractures are the most common pelvic fractures.4
Anteroposterior compression fractures are caused by a force travelling from the front to the back of the pelvis. They are also known as ‘open-book’ fractures.4
Vertical shear fractures are caused by a force being transmitted up through the leg and acetabulum and disrupting the sacroiliac joint. 4
Patients can have more than one type of fracture concurrently. Concomitant lateral, anteroposterior, or vertical fractures is referred to as a combined mechanism fracture. 4,7
Type I
Sacral compression fracture and pubic rami fracture on side of impact Stable
Type II
Type III
Type I
Sacral compression fracture, pubic rami fracture, and iliac crescent fracture on side of impact
Type I or II injury on one side and anteroposterior compression injury on the opposide side
Vertically stable Rotationally unstable
Pubic diastasis of less than 2.5cm Stable
Type II
Type III
Pubic diastasis of more than 2.5cm and widening of anterior sacroiliac joint Vertically stable Rotationally unstable
Hemipelvis separation with complete disruption of pubic symphysis and posterior ligament complexes Unstable
Vertical shear fracture Displacement of hemipelvis; fractures of the rami pubis sacroiliac joint
Other pelvic fractures
An acetabular fracture is a break in the socket of the ‘ball-and-socket’ hip joint caused by an axial loading of the femur.1
Avulsion fractures are generally caused by a forceful muscular contraction.1 The most common sites are the anterior superior iliac spine, anterior inferior iliac spine, and ischial tuberosity.1
Assessing a patient for pelvic trauma should be part of a structured assessment of the patient in the context of a polytrauma assessment and management.3
High energy pelvic trauma, like all major traumas, require a primary survey with the initial aim of identifying and managing immediate threats to life.4 After the primary survey has been completed and the patient has been stabilised, a secondary survey, involving a systematic head-to-toe examination, should be performed to identify other significant but not immediately life-threatening injuries. 4
Signs and symptoms of pelvic trauma
Pelvic injury should be suspected in all patients with a significant mechanism of injury (motor vehicle crashes and collisions with pedestrians, falls from height, and crush injuries).1,3,4 Signs of pelvic trauma include:9
• Haemodynamic compromise
• Pelvic asymmetry or instability
• Limb shortening or external rotation
• Paraesthesia in upper thighs or genital area
• Reduced or absent power in lower limbs
• Pain
• Scrotal, vulval, or retroperitoneal bruising or swelling
• Vaginal, rectal, or urethral meatus bleeding. Pelvic assessment trauma diagnosis
Assessment of the pelvis following high energy trauma should be performed with extreme care to avoid haemorrhage aggravation if the pelvis is fractured.3 A pelvic examination includes:3
• Inspecting for wounds, ecchymosis, obvious deformity, and asymmetry
• Palpating the pubic symphysis, iliac crests, posterior sacroiliac joints, ischial tuberosities, and the spine extending inferiorly to the sacrum and coccyx
• Assessing for instability by gently compressing the iliac crests (this should be performed only once).
A pelvic examination should not include rocking or springing on the pelvis.3
Clinical examination in an alert adult patient can effectively exclude significant pelvic injury with 93-100% sensitivity unless there are distracting injuries.3
Patients with suspected pelvis fractures should also be assessed for rectal injury, genital or perineal trauma, abdominal tenderness, distention, or signs of trauma, and lower limb length discrepancy, malrotation, and neurology.1,3
Diagnostic imaging
Imaging can determine the location of a pelvis fracture, the number of affected bones, and whether the trauma has damaged surrounding soft tissues, blood vessels, or nerves.3
The gold standard for diagnosing pelvic ring injuries is contrast-enhanced abdominopelvic CT scan due to its high sensitivity and detailed delineation of fractures.1,3,4
A pelvis x-ray is indicated for patients who are haemodynamically unstable, who have an altered mental state or distracting injuries, and who are not having an abdominopelvic contrast enhanced computed tomography (CT) scan for any other reason.3
Pelvic trauma management
The management priorities for a high energy pelvic trauma are haemorrhage control, restoration of blood volume, pelvic stabilisation, and pain relief.4
Haemhorrage control and blood volume
Patients with high energy pelvic trauma are at a significant risk of haemorrhage.4 Pelvic fractures can disrupt the blood vessels in proximity to pelvic bones and cause internal haemorrhage, shock, and death.2
Approximately 10% of pelvic fractures are associated with haemodynamic instability as a result major vessel disruption in the pelvic cavity.4
When the tamponade effect of the pelvic ring is lost, large quantities of blood can collect in the retroperitoneal cavity.4
The state of the patient’s circulatory system should be assessed and regularly monitored by checking their heart rate and blood pressure.4 Neuromuscular observations should also be undertaken including pedal pulses, capillary refill, warmth, and skin colour.4 A FAST ultrasound scan can also be used to assess for intraperitoneal fluid.3
Haemodynamically unstable patients with isolated pelvic trauma can be managed through a combination of angiographic embolisation, surgical peritoneal packing, and mechanical pelvic stabilisation.4
Any person with suspected pelvic fractures must not be log rolled before bleeding is ruled out by imaging. Log rolling causes movement of the pelvis and is associated with haemodynamic instability caused by blood clot disruption. 4
Blood volume may be restored by administering blood products.4
Pelvic stabilisation
Pelvic stabilisation is an important intervention in managing severe pelvic trauma.3 The main objectives of pelvic stabilisation are: 3,4
• Preventing re-injury and clot distruption
• Reducing pelvic volume
• Tamponading bleeding pelvic bones and vessels
• Decreasing pain.
Methods of pelvic stabilisation include pelvic binders, C clamps, and anterior external fixation.3,8
Pelvic binders are recommended as a primary strategy in applying compression and stabilising
the pelvis.8 To be effective the binder must be positioned correctly, over the greater trochanters, to bring the pelvic bones closer together and splint the pelvis.4,8 The goal is to approximate normal anatomic alignment and care must be taken not to over-tension the binder to reduce the pelvis beyond its normal anatomical position.3 If a pelvic binding device is not available a sheet can be wrapped around the pelvis and secured by tying or clamping the ends.3
Tying the feet together can help to maintain anatomical position of the pelvis. 3
Pelvic binders should be removed within 24 hours.4 If ongoing stabilsation is required the binder should be replace by C clamps or anterior external fixation.8
Patients with high energy pelvic trauma should have their pain regularly assessed using a suitable pain assessment tool. Patients will require analgesia during the assessment process, and while stabilising the pelvis will reduce pain, patients will still require analgesia. 4
1. Tomberg S, Heare A. Pelvic trauma: Initial evaluation and management. 2022 [cited 2023 Apr 16]. In: UpToDate [Internet]. Waltham (MA): UpToDate Inc. Available from: https://www.uptodate.com/contents/ pelvic-trauma-initial-evaluation-andmanagement
2. Tullington JE, Blecker N. Pelvic Trauma. 2023 [cited 2023 Apr 16]. In: StatPearls [Internet]. Treasure Island (FL): StatPearls Publishing LLC. Available from: https://www. ncbi.nlm.nih.gov/books/NBK556070
3. Chris Nickson. Life in the Fast Lane [Internet]. Pelvic Trauma; 2020 [cited 2023 Apr 16]. Available from: https://litfl.com/ pelvic-trauma
4. Charsley J, Jarman H. Assessment and management of pelvic fractures from high-energy trauma in adults. Emerg Nurs [Internet]. 2023 [cited 2023 Apr 16]. doi: 10.7748/en.2023.e2151
5. Burlew CC, Moore EE. Severe pelvic fracture in the adult trauma patient. 2022 [cited 2023 Apr 16]. In: UpToDate [Internet]. Waltham (MA): UpToDate Inc. Available from: https://www.uptodate.com/contents/ severe-pelvic-fracture-in-the-adult-traumapatient
6. Campagne D. Pelvic Fractures. 2022 [cited 2023 Apr 16]. In: MSD Manual Professional Version [Internet]. Kenilworth (NJ): Merk Sharp & Dohme Corp. Available from: https://www.msdmanuals.com/en-au/ professional/injuries-poisoning/fractures/ pelvic-fractures
7. Chris Nickson. Life in the Fast Lane [Internet]. Classification of Pelvic Fractures; 2020 [cited 2023 Apr 16]. Available from: https://litfl.com/classification-of-pelvicfractures
8. Benders KE, Leenen LP. Management of Hemodynamically Unstable Pelvic Ring Fractures. Front Surg [Internet]. 2020 [cited 2023 Apr 16]. doi: 10.3389/ fsurg.2020.601321

The Bureau of Meteorology will collaborate with the European Centre for MediumRange Weather Forecasts (ECMWF) to improve data sharing and long-range forecasting abilities.
The collaboration with the ECMWF is part of the Copernicus Climate Change Service, the Earth observation component of the European Union’s space programme. It includes satellite and in situ observations and modelling for a range of services such as monitoring climate change.
A five-year agreement was signed by the Bureau’s CEO and Director, Dr Andrew Johnson, and the Centre’s DirectorGeneral, Dr Florence Rabier.
“This new agreement enables the Bureau to access more comprehensive data from some of the world’s best forecast models to support and improve its own services,” Dr Johnson said.
“It also provides more opportunities for joint research projects exploring weather and climate impacts in the southern hemisphere and around the globe.”
“The benefits of this partnership will lead to future improvements in Australian weather and climate products and services for the benefit of the Australian community.”
Dr Rabier said the agreement incorporated long-range global forecasts from the Bureau of Meteorology’s Australian Community Climate and Earth System Simulator (ACCESS) into Copernicus. ACCESS uses ocean, atmosphere, ice and land observations to create long-term forecasts.
“ACCESS will join other world-leading models, demonstrating the importance of scientific collaboration and of Australia’s
contribution to the international community.
“This is an important ongoing partnership for ECMWF, the benefits of which will be felt worldwide in the ensemble forecasts produced. It will also lead to further improvements in weather and climate modelling and research conducted in Europe and Australia.”

An expert in medical negligence law is encouraging women to speak up and insist on triple test breast examinations, in light of a reported increase in late or missed diagnosis of breast cancer.
Cancer Australia recommends triple test breast screening when investigating new breast symptoms. The triple test involves patient history and clinical breast examination; mammography or ultrasound imaging; and the use of non-excisional biopsy.
However, Senior Associate in Medical Negligence at Slater and Gordon, Bridie Walsh, said cases of delayed diagnosis where the practitioner has failed to undertake the triple test are still common.
“Breast cancer remains a devastating but common reality for so many Australians. According to Cancer Australia, it is estimated that a person has a 1 in 15 risk of being diagnosed with breast cancer by the age of 85, and for women specifically it is a 1 in 8.
“It is concerning to have noticed an increase in clients who have had either missed or delayed cancer diagnosis, especially when most of these clients are women.
“Regular breast checks are an important part of medical care, but sometimes they aren’t enough to properly determine if cancer is there, which is where a triple test breast examination comes in.
Ms Walsh said early cancer diagnosis plays a major role in the extent of treatment, and the eventual outcome.
“I would like to encourage all women to speak up when they feel a lump and to insist on the triple test, as this can potentially save your life.”

The Australian Dental Association (ADA) has said that thousands of children are being hospitalised unnecessarily every year for entirely preventable oral health conditions, and that this trend is getting worse.
The ADA’s Oral Health Tracker shows almost 11 in every 1,000 children aged 5 to 9 years old were admitted to Australian hospitals for preventable dental conditions in 2021-2022, compared to 9.5 per 1,000 in 2018.
ADA President Dr Scott Davis said there are complex reasons behind this issue.
“It’s hard to believe in a first world country like Australia, with most people having access to fluoridated water, healthy food and the tools for keeping mouths clean and decay-free that this is still happening – but it is,” Dr Davis said.
“Cost is always an issue and this continued trend of children needing to go to hospital to get their oral health problems fixed, indicates that we have a significant problem today and for the future.
“Every state and territory provides free dental care for eligible children so they can see a private or public dentist under the Child Dental Benefits Schedule - but there needs to be considerably more effective, targeted publicity of the scheme as it’s currently only used by 38 percent of eligible families.”
The ADA said that high rates of dental decay and sugar consumptions play a big part in this issue, with 70 percent of kids aged 9-13 and 73 percent of young people aged 14-18 having too much sugar. Sugary drinks are a main culprit: 37 percent of kids have 2-5 drinks of fruit juice a week and the same number have 2-5 soft drinks a week, although not necessarily the same kids.
According to the ADA the issue is compounded for infants and children as some dental work requires general anaesthetic, and a flawed funding model delays the urgent surgery they need.
“The current hospital funding model means dental cases are less lucrative for private hospitals than other types of operations like cataracts and grommets, so access to surgery theatre time for dental procedures has been slashed,” Dr Davis said.
“The result is infants and children are having their operations postponed or cancelled and they’re waiting a long time, often in considerable pain or on pain relief, before their problem is fixed under general anaesthetic."
Australia’s national science agency, CSIRO, announced that Dr Debbie Eagles has been appointed as the organisation’s new Director of the Australian Centre for Disease Preparedness (ACDP).
Prior to this, Dr Eagles was ACDP Deputy Director. According to a statement release by the organisation, she played a pivotal role in CSIRO’s response to the COVID-19 pandemic.
Dr Eagles will lead CSIRO’s highcontainment facility in Geelong, Victoria,
which helps protect Australia’s livestock and aquaculture industries, as well as protecting the community from emerging infectious disease threats.
Executive Director, Future Industries, Ms Kirsten Rose, said Dr Eagles has held science leadership roles in CSIRO for many years, and she has already helped guide and shape the future direction of the ACDP.
Before Dr Eagles was the ACDP Deputy Director, she spent three years as Research Director for CSIRO’s Diagnosis, Surveillance and Response Program, following eight years in the Veterinary Diagnostic Team.
“Our ACDP facility is an integral part of Australia’s biosecurity infrastructure and is vital in ensuring we can continue to protect and prepare Australia from biothreats and emerging infectious and zoonotic diseases,” Ms Rose said.
“Dr Eagles has an impressive track record and is well placed to continue to lead the work required to elevate ACDP further and keep us supporting Australia well into the future.”
A statement released by CSIRO said Dr Eagles is a veterinary epidemiologist with a background in vector-borne diseases and that she brings a wealth of experience in animal health and biosecurity preparedness in Australia and the Asia Pacific region.
She is internationally renowned as a World Organisation for Animal Health (WOAH) Reference Laboratory Expert on Bluetongue Virus, and is a WOAH and Australian Qualified Expert on the UN Secretary-General Mechanism’s Roster for investigations of Alleged Use of Chemical, Biological or Toxin Weapons.
WA children will have access to further protection from serious illness, with the recent announcement of WA Department of Health funding for infant immunisation for RSV disease.
According to the WA Government, the RSV preventative medicine, nirsevimab, is available through the RSV infant immunisation program.
“Nirsevimab is a long-acting monoclonal antibody that has been registered by the TGA for use in young infants entering their first RSV season and some children entering their second RSV season who have medical conditions that place them at high risk of severe RSV illness,” the WA Government said in a statement.
“Nirsevimab has been shown to be 80 percent effective at preventing young infants from being hospitalised with lower respiratory tract infection (LRTI) caused by RSV. Nirsevimab is 90 percent effective at preventing an infant from being admitted to an Intensive Care Unit because of LRTI caused by RSV.”
The Immunisation Foundation of Australia, said the decision will keep hundreds of WA babies out of hospital.
“WA is a leader in the fight against vaccine-preventable diseases.” Catherine Hughes AM, Founder and Director of the Immunisation Foundation of Australia said.
“It was one of the first to adopt a maternal whooping cough immunisation program, the first to provide influenza vaccines for children, and will now be the first to protect all infants against severe RSV.”
Nirsevimab, known by brand name Beyfortus, is widely used in Europe and the US.
“With an average of 12,000 RSV-related hospitalisations among Australian infants each year, broad access to Beyfortus has the potential to ease the strain on families and our hospital system during the winter months,” Ms Hughes said.
The immunisation program will run from early April to September 2024.


The World Health Organization (WHO) has announced a $4 million grant fund for organisations working in pathogen genomic surveillance.
According to the WHO the fund will support projects across the world, particularly in low and middle income countries, to help scale-up pathogen genomic surveillance and help countries respond more quickly and effectively to prevent outbreaks.
“Pathogen genomics analyses the genetic code of viruses, bacteria and other disease-causing organisms to understand, in conjunction with other data, how infectious they are, how deadly they are, and how they spread,” a WHO statement said.
With this information, scientists and public health officials can identify and track pathogens to prevent and respond to outbreaks as part of a broader disease surveillance system, and to develop treatments and vaccines.
WHO Director for Collaborative Intelligence Sara Hersey said genomic surveillance is a critical tool in responding to public health threats.
“However, access to genomics has been highly uneven, and there is a risk that the incredible capabilities built up during the COVID-19 pandemic will be lost as the world’s focus shifts,” Ms Hersey said.
“The new fund will support the sustainable implementation of genomic surveillance in countries at all income levels, outside of pandemics, so that we can maintain these critical capabilities within national health systems.”
The initial grants for the fund were provided by the Bill & Melinda Gates Foundation, The Rockefeller Foundation and Wellcome.
Director of Infectious Disease at Wellcome
Alex Pym said pathogen genomics and surveillance can tell us which pathogens exist in a population and how they are transmitting and evolving.
“These are key tools for researchers, policy-makers and health-care workers to rapidly identify and respond to outbreaks or the emergence of drug-resistant strains,” Mr Pym said.
“This can have a huge impact on protecting lives – especially in regions with fewer resources.”

A 52-year-old man from Rochdale, Greater Manchester, has been charged with drinkdriving after he called police to report himself for drink-driving.
After reporting himself, he then quite helpfully provided authorities with additional information allowing them to locate and arrest him.
North Yorkshire Police seem slightly taken aback by the situation.
“Well it’s not every day that a suspected drink driver dobs themselves in to the police,” a police statement said.
Police received a call from a man who said that he was: “drink driving and doesn’t know what he is doing.”
The man then told the 999 police call handler he was in the Knaresborough area and that he had a heavy weekend. The Force Control Room immediately sent officers to the area. The call handler obtained further information from the caller, and officers on the ground quickly located the man’s vehicle.
A roadside breath test was carried out at the side of the road. The driver blew 118 micrograms of alcohol in 100 millilitres of breath, the legal limit in the UK is 35 micrograms. The man was arrested on suspicion of drink-driving. In the follow up breath-test at the police station, the man recorded 123 micrograms of alcohol in 100 millilitres of breath.
He was briefly held in custody before being bailed to appear at Harrogate Magistrates’ Court.

The Bellevue Police Department bomb squad was called to a house in Washington State following a report that a military grade rocket was being stored in the garage.
According to the Bellevue PD blog, police were alerted to the potential threat when they received a call from an Air Force Museum in Dayton, Ohio. Staff at the museum had received a call from a Bellevue resident looking to donate the rocket.
This resident stated the rocket had belonged to a neighbour of his, who had recently died. The neighbour bought the item from an estate sale.
The Bellevue PD bomb squad were dispatched to the house to inspect the rocket. The rocket was determined to be a Douglas AIR-2 Genie, designed to carry a 1.5 kiloton nuclear warhead.
Fortunately, there was no warhead attached, nuclear or otherwise. The rocket was confirmed to be inert and not an explosive hazard.
Bellevue PD said the rocket was inert and the military did not want it back. Police left it with the resident to be restored and sent to a museum.

Statistics released by the World Health Organization (WHO) show that while global deaths fell slightly to 1.19 million per year in 2023, road crashes remain a persistent global health crisis, with more than two deaths occurring every minute, or about 3,200 a day.
According to the WHO global status report on road safety 2023, since 2010, road traffic deaths have fallen by 5 percent to 1.19 million annually with pedestrians, cyclists and other vulnerable road users making up just over half of all deaths.
Deaths among car and other four-wheeled light vehicle occupants fell slightly to 30 percent of global fatalities. However, 53 per cent of all road traffic fatalities are vulnerable road users including: pedestrians (23 percent); riders of powered two-andthree-wheelers such as motorcycles (21 percent); cyclists (6 percent); and users of micro-mobility devices such as e-scooters (3 percent).
WHO Director-General, Dr Tedros Adhanom Ghebreyesus said the reduction in fatalities was a positive sign, but more needs to be done.
“The tragic tally of road crash deaths is heading in the right direction, downwards, but nowhere near fast enough,” Dr Ghebreyesus said.
“The carnage on our roads is preventable. We call on all countries to put people rather than cars at the centre of their transport systems, and ensuring the safety of pedestrians, cyclists and other vulnerable road users.”
According to the report about 90 percent of traffic deaths occur in low and middle income countries, and fatalities in these countries are disproportionately higher when set against the number of vehicles and roads they have.
The risk of death is three times higher in low-income than high-income countries, yet low-income countries have just 1 percent of the world’s motor vehicles.
United States Customs and Border Protection (CBP) in Boston has seized four deceased and dehydrated monkeys from an individual passing through Logan Airport on the way back from the Democratic Republic of Congo, via France.
In a statement regarding the incident CBP said that upon the arrival of foreign flights to Logan Airport, CBP Canine (K9) units will perform a preliminary screening of baggage. In this case the K9 unit, Buddey, found something suspicious.
“During the screening of Delta flight 225 from Paris, CBP K9 Buddey alerted his
handler to a specific piece of luggage,” the CBP statement said.
“When questioned about the bag, the passenger declared that it only held dried fish. The luggage was x-rayed and appeared to hold dried fish. Still, upon physical inspection, the officer identified the dead and dehydrated bodies of four monkeys.”
“Raw or minimally processed meat from wild animals in some areas of the world, including Africa, is referred to as ‘bushmeat.’ Bushmeat comes from a variety of wild animals, including bats, nonhuman primates (monkeys), cane rats (grasscutters), and duiker (antelope), and may pose a communicable disease risk. These types of meats are not allowed entry into the United States.”
Upon discovering the mummified monkey remains, the CBP immediately contacted the Center for Disease Control (CDC) which, in the US, is the agency with regulatory authority over primate material.
The CDC requested that the luggage containing the bushmeat be seized and that Delta Airlines either destroy or return the bags to France.
The four kilograms of bushmeat was detained for the CDC and marked for destruction.
Julio Caravia the Area Port Director – CBP Boston, said the he potential dangers posed by bringing bushmeat into the United States are real.
“Bushmeat can carry germs that can cause illness, including the Ebola virus. The work of CBP’s K9 unit and Agricultural Specialist were vital in preventing this potential danger from entering the U.S.,” Mr Caravia said.


New studies by La Trobe University have reported that the additional responsibilities women assumed during the COVID-19 pandemic influenced a spike in drinking among working mothers.
According to La Trobe University, participants in the study noted “a lack of control they felt over their everyday lives and drinking as they juggled working from home, parenting, household, and teaching roles combined with the limit on socialised activities outside the home.”
The two studies were comprised of the same sample and interviewed 22 Australian women over five months in 2022, who mostly identified as professional workers between the ages of 36 and 51.
They described feeling overburdened during COVID-19 restrictions because of their increased workload and lack of organisational support, contributing to heightened alcohol consumption.
“We were all stuffed, it was horrible. We were all working and trying to home school and it was just so awful … and so, I guess, my girlfriends were going through that too, the ones with kids, and they were all definitely drinking a lot more,” one study participant said.
“It was probably the homeschooling that really made me crack,” another study participant said.
Lead researcher and PhD candidate Maree Patsouras, at the Centre for Alcohol Policy Research, said drinking alcohol for many women became a coping mechanism to surviving the day. However, the attitudes towards drinking shifted from pleasure to negative connotations as the study progressed.
“In the short term, women justified their alcohol consumption by wanting to relax and have some enjoyment,” Maree said.
“They explained there was little to look forward to during the lockdowns, with the absence of their usual activities, and the perception of alcohol as a reward was amplified.
“But the meanings associated with alcohol later conflicted with the earlier discussions to wanting to forget their days and ease the stress.”
Most working mothers described increased alcohol consumption often in terms of frequency, particularly on weekdays, during the lockdowns. Some women also reported that they increased the quantity by pouring extra or larger glasses.
“Before COVID, maybe one or two nights a week and it would be a couple of glasses of wine. It wasn’t anything in excess, but then during COVID it became a bottle of wine sometimes,” one study participant said.
Others reported their drinking style as distinctly different to men, where drinking occurred in the blurred transition between working and parenting roles. Maree said this highlights the research and its relevance beyond pandemic restrictions.
“Many women said they noticed more alcohol advertisements and when the opportunity came to meet with their friends, it often revolved around having a drink together as opposed to being able to exercise or socialise in other regular ways pre-COVID,” Maree said.
“Some women joked about alcohol use and how they would send photos of their wines to friends, with memes being shared around.
“So, it was just very pervasive during the lockdowns, and it supports other research that shows how advertisements used COVID-19 restrictions to promote alcohol as well.”
Researcher Dr Gabe Caluzzi said this period of social change highlighted the tendency for people to fall back into traditional gender roles and provides a case study for better arrangements in the event of a future disaster.
“While we only interviewed women, many were expected to do the mothering, the homeschooling, even while they were working and this played into women’s frustrations with COVID-19 restrictions and part of their reasons for drinking,” Dr Caluzzi said.
“There’s a need for a structural approach to the way women drink as it can be tied to varying gender roles, such as drinking for pleasure because they’re frustrated or not coping.
“It’s about making sure that women are supported in workplaces and in their homes and that there are resources for women to access, whether that’s childcare or homeschooling, so that not all the burden is placed on themselves to manage these tasks.”

More Australians are under more financial stress than at any time before the COVID-19 pandemic, according to a new study from The Australian National University (ANU), with many finding it hard to get by on their current income.
The survey was conducted in January 2024 as part of the ANUpoll series, which has been tracking the views of Australians since 2008. The most recent survey draws on responses from more than 4,000 people across the country.
ANU Professor Nicholas Biddle said this stress has also most likely contributed to a decline in confidence in government.
“In January 2024, we estimate that 34.2 percent of Australians were finding it difficult or very difficult to get by on their current income,” Professor Biddle said.
“This is the highest rate we have observed at any time since February 2020, and well above the average over the preceding four years.”
According to the study, many Australians have also reported taking some form of action in response to this financial pressure. Over 62 percent of those surveyed said they spent less on groceries and essential items, and more than 56 percent postponing major purchases.
“We also saw a decline in Australians’ satisfaction with their own life. The average was 6.55 on a scale of one to 10, far lower than the numbers we observed in 2019, 2020 and 2023,” Professor Biddle said.
According to the ANU the survey had a particular focus on Australian’s views on the housing market. Since April 2017, the percentage of Australians who are falling behind with their loan or rent payments has more than doubled, from 2.2 percent to 4.8 percent, and there has also been a 4.8 percent increase in the share of Australians who find their housing payments a constant struggle.
“But perhaps the most dramatic change in the housing market is the proportion of Australians who think owning one’s own home is part of the Australian way of life. There was a large decline from April 2017, when 74.9 percent said it matters a lot, to 65.8 percent in January 2024,” Professor Biddle said.
Australian researchers from La Trobe University, University of Melbourne, Healthscope, and The Royal Women’s Hospital, have discovered new ways to support women during menopause. Researchers believe a new approach needs to go beyond medical treatments to include information on symptoms and treatment options, as well as empathic clinical care and workplace adjustments.
According to a statement released by La Trobe, greater awareness, better understanding of mechanisms, new treatments and additional support for people who experience early menopause, menopause after cancer treatment or who are at a higher risk of depression over the menopause transition, is urgently needed.
La Trobe’s Academic and Research Collaborative in Health’s Executive Director Professor Meg Morris said it was vital for women to discuss menopause as part of a healthy ageing process.
“Being open about menopause reduces the stigma about it and makes it part of everyday life, which it is for millions of women every day,” Professor Morris said.
“The study shows that women can be empowered to navigate this life stage if they have the acknowledgement and support of health professionals, researchers, their workplaces, and society as a whole.
“Menopause is not a medical condition or a decline in a woman’s health, but is often seen as such by society, and this is the type of thinking we need to challenge."
Study lead author Dr Lydia Brown from the Healthscope ARCH, and The University of Melbourne said the research team showed that women needed accurate, consistent and impartial information to make informed decisions.
“This may include taking hormone therapy and psychological therapies to reduce the symptoms,” Dr Brown said.
“In Australia we are becoming more open to discussing menopause in our workplaces, in the media, and in politics."
Dr Brown said while some women had negative experiences of menopause and benefitted from hormone therapies, that was not the whole picture.
“The reality is much more complex and varied, with some women reporting neutral experiences and others highlighting good aspects, such as freedom from menstruation and menstrual pain,” Dr Brown said.


Australian Nursing Federation member and nurse Chelsea Luberacki is always on the lookout for new opportunities to learn and grow within her profession, and this is something she really appreciates about her role working as a theatre nurse.
Chelsea has been working as a nurse for eight years now, and she has never stopped looking to learn more and get more experience. This drive has even taken her overseas, working as a theatre nurse in the UK for two and a half years.
She trained to be a nurse at Edith Cowan University Joondalup, but her journey in healthcare starter before that.
“I liked science in high-school, and I found human biology most interesting,” Chelsea said.
After finishing her training Chelsea got a job in General Practice.
“I worked in a General Practice in Joondanna.
“It was a new practice and was very quiet with only one doctor working most days. I worked there for one and a half years before moving on to work in a busier general practice."
She remained in General practice for another year and a half, before being presented with an opportunity that would change her life.
“I moved to the United Kingdom for two and a half years to work in theatre after working in General Practice for three years, and it was the best thing I ever did.
“I gained so much experience working over there.”
In fact, one of Chelseas best memories from her years in nursing comes from the time she spent overseas.
“While I was working in the United Kingdom we had a patient arrive to hospital via helicopter after a car accident, and I scrubbed for my first major orthopedic case on my own.

“I had 20 trays of instruments, multiple surgeons working with me, and I managed to complete the case even though it took my entire shift to help this patient.
“I was incredibly proud of myself that day.”
On her return to Australia, Chelsea decided to continue working in the same field as she had been in the UK.
“I work as a theatre nurse at Hollywood Private Hospital and St John of God Subiaco Hospital. I absolutely love theatre nursing.
“Working in theatre gives me the opportunity to learn something new every day. Every shift is different and that keeps the job interesting. “

Of course, like many who work in this profession, Chelsea also sees many of the problems that face healthcare workers. Even with these challenges, Chelsea knows exactly how important her job is.
“Without nurses the doctors would not be able to do this job as effectively and as a result people would be suffering for longer. Nurses are vital to healthcare,” Chelsea said.
“We are always under-staffed which makes it quite difficult to teach new staff our job."
Chelsea joined the ANF two years ago, to ensure she had all the protections and support she needed, something she has never regretted.
“A friend suggested it to me, telling me all the benefits, and I was sold!
“Honestly, I like knowing that I am supported and if anything was to ever go wrong in my workplace, I have the ANF to support me. The discounts and CPD are a much-appreciated added bonus!”

Looking back on her career in nursing so far, Chelsea's noted that many of the skills you learn as a nurse can also apply to all aspects of life, and that working as a nurse is about seizing on the opportunities presented to you.
“Communication is everything! In theatre especially every team member needs to be aware of what is going on. This can be applied to everyday life too.
“Working as a nurse gives you so many opportunities throughout the course of your career. There are so many different nursing jobs all over the world!”
Chelsea was also one of our recent runners-up in the Western Nurse photo competition. We hope she enjoys the prizes.


Australian company MediSecure, which provides electronic prescription services allowing people to get scripts from their doctors online, is the latest victim of a ransomware data breach.
MediSecure confirmed the breach, releasing a statement on its website.
“MediSecure has identified a cyber security incident impacting the personal and health information of individuals. We have taken immediate steps to mitigate any potential impact on our systems,” the statement said.
“While we continue to gather more information, early indicators suggest the incident originated from one of our third-party vendors.
“MediSecure takes its legal and ethical obligations seriously and appreciate this information will be of concern. MediSecure is actively assisting the Australian Digital Health Agency and the National Cyber Security Coordinator to manage the impacts of the incident. MediSecure has also notified the Office of the Australian Information Commissioner and other key regulators.”
The National Cyber Security Coordinator Michelle McGuiness released a statement on Twitter/X saying she had been advised by the then unnamed company that “it was the victim of a large-scale ransomware data breach incident.”
The statement went on to say the National Cyber Security Coordinator would be working with agencies across the Australian Government, states and territories to coordinate a whole-ofgovernment response to this incident.
“The Australian Cyber Security Centre is aware of the incident and the Australian Federal Police is investigating,” Ms McGuiness said.
“We are in the very preliminary stages of our response and there is limited detail to share at this stage.”
Less than two years ago Medibank Private was also subject to a ransomware attack that saw 9.7 million records stolen, including names, dates of birth, Medicare numbers and sensitive medical information. Some records were published on the dark web.
The Australian Federal Police have played a critical role in the disruption of the ransomware group allegedly responsible for running LockBit, which has caused billions of dollars’ worth of harm across the globe, including millions to Australian individuals and businesses.
Along with agencies from ten other countries, the AFP was part of Operation Cronos, a Europol-led investigation that led to the disruption of LockBit’s critical infrastructure.
According to a statement released by Europol, the months-long operation resulted in the compromise of LockBit’s primary platform and other critical infrastructure.
“This includes the takedown of 34 servers in the Netherlands, Germany, Finland, France, Switzerland, Australia, the United States and the United Kingdom,” the statement said.
“In addition, two LockBit actors have been arrested in Poland and Ukraine at the request of the French judicial authorities. Three international arrest warrants and five indictments have also been issued by the French and US judicial authorities. Authorities have frozen more than 200 cryptocurrency accounts linked to the criminal organisation, underscoring the commitment to disrupt the economic incentives driving ransomware attacks.”
Investigators gathered a huge amount of data which will help law enforcement in further operations.
A statement released by the AFP said LockBit was known to criminals as a “ransomware-as-a-service” product, meaning criminals with limited technological skills could purchase and use a ready-made ransomware program.
“Cybercriminals use ransomware to extort payments from victims in exchange for the recovery of, and ability to regain access to the encrypted data,” the statement read.
Assistant AFP Commissioner Scott Lee said the international investigation was a significant breakthrough in the global fight against cybercrime.
“Cybercrime is not restricted by borders and tackling this crime type requires a united, global response from law enforcement,” Assistant Commissioner Lee said.
“The AFP continues to work closely with our international law enforcement partners, as demonstrated through the recent disruption of the BlackCat ransomware group.
“This latest takedown is yet another example of the powerful outcomes that can be achieved through a united law enforcement front.
“This investigation has not only taken down the world’s most prolific ransomware group, but also damaged the group’s reputation and credibility beyond repair. We have obtained a vast amount of data from investigations so far and will continue to follow all leads and bring those responsible to justice.”

1 Medical test conducted by a surgeon, involving the extraction of sample cells or tissues (6)
5 A full --- of a human pregnancy is 280 days or 40 weeks (4)
9 Stranger, more bizarre (5)
10 Organ that detects light and converts it to electro-chemical impulses (3)
11 Device used as a receptacle for urine or faeces of a patient confined to be (6)
13 What you may yell out when you experience a minor bodily injury (4)
15 Long period of time (4)
16 Chest pain or discomfort that keeps on coming back (6,8)
20 The human spirit (4)
22 Prostaglandin, a balloon catheter, artificial breaking of the waters and oxytocin are all used to --- labour (6)
24 Collection of concubines (5)
25 Stops the flow of blood, eg (5)
27 Wealth (9)
28 Cherub (5)
30 This year’s --- prize in Physiology or Medicine was awarded to the American physician Drew Weissman (5)
31 Sister ---, disco family (6)
33 With mouth open wide in shock (4)
35 A condition in which the protective plate at the tip of a foot digit digs back into the flesh (7,7)
39 Church song (4)
41 Immediately, in medical jargon (4)
42 Relish and enjoy taste and flavour (6)
45 Less insane (5)
46 Follow on as a consequence (5)
47 --- Stravinsky, Russian composer (4)
48 Fattest and stubbiest of the hand digits (6)
DOWN
1 Move the uppermost part of the body as a sign of agreement (3)
2 Senior (3)
3 Over there (archaic) (3)
4 Saying, proverb (5)
5 --- pout, what some people with bad lip fillers end up with (5)
6 Expression of indifference or boredom (3)
7 Mendelian ---, basic unit of heredity (4)
8 Viral disease characterized by a nasty skin rash with blisters in localised areas, also known as herpes zoster (8)
12 Dame Everage (4)
14 Marie ---, Polish/French physicist who pioneered the use of radioactivity (5)
15 Valuable item or possession (5)
17 In terms of BMI, 18.5-24.9 is considered the --- range (6)
18 Sore (7)
19 Rotter, rogue (3)
21 Medical substance used to treat a disease or ailment (4)
23 Happy, pleased with one’s circumstances (7)
24 Cranial discomforts (9)
25 Showing weakness or diseases of age, especially a loss of mental faculties (6)
26 --- palsy, paralysis of the arm caused by injury to the upper group of the main nerves supplying it (3’1)
29 --- Marbles, collection of ancient Greek sculptures (5)
31 One of the five bodily senses (5)
32 Morning moisture (3)
34 In ---, instead of (4)
36 The epidermis is the --- layer of the skin (5)
37 Hospital worker (5)
38 Beginning of a disease or decline in bodily function, eg (5)
40 On the ---, recovering from an illness (4)
41 --- Lanka, island (3)
43 SI unit of electrical resistance (3)
44 Reactive species capable of causing damage to biomolecules, leading to tissue injury (3)
Read this article and complete the quiz to earn 0.5 iFolio hour
Read this article and complete the quiz to earn 1 iFolio hour
Brand names: Eliquis1
Drug class: anticoagulants1
MECHANISM OF ACTION
Apixaban is a highly selective factor Xa inhibitor.1,2 By inhibiting factor Xa, apixaban blocks the propagation phase of the coagulation cascade, preventing the production of thrombin, the conversion of fibrinogen to fibrin, and thrombus development.1,2,3
ADMINISTRATION
Apixaban is administered orally in tablet form. 1
INDICATIONS
Indications for apixaban are:1,3
• Prevention of venous thromboembolism following elective knee or hip replacement
• Prevention of stroke and systemic embolism in patients with non-valvular atrial fibrillation and increased stroke risk
• Treatment, and prevention of recurrent, deep vein thrombosis (DVT) and pulmonary embolism.
CONTRAINDICATIONS
Apixaban is contraindicated in patients with: 1,3
• Hypersensitivity to apixaban
• Pharmacological or spontaneous impairment of haemostasis
• Severe active bleeding or disease states with an increased risk of severe bleeding, such as severe thrombocytopenia, severe uncontrolled hypertension, gastrointestinal ulceration, and vascular aneurysm
• Hepatic impairment associated with coagulopathy and an increased risk of bleeding
• Severe renal impairment with creatinine clearance of less than 25mL/minute.
INTERACTIONS
Apixaban is metabolised by CYP3A4 (a drug metabolising liver enzyme) and is a substrate of P-glycoprotein.4 CYP3A4 and P-glycoprotein inhibitors, such as amiodarone, itraconazole, clarithromycin, ketoconazole, and ritonavir, may inhibit the metabolism of apixaban, increasing its concentration and the risk of bleeding.3,4 Concurrent use of apixaban and strong inhibitors of both CYP3A4 and P-glycoprotein is contraindicated.1
Conversely, CYP3A4 and P-glycoprotein inducers, such as carbamazepine, rifampicin, phenytoin, phenobarbital, and St John’s wort, may increase the metabolism of apixaban, decreasing its concentration and reducing its efficacy.2,3,4 Concurrent use of apixaban for the treatment of DVT and pulmonary embolism and strong CYP3A4 and P-glycoprotein inducers should be avoided.3,4 If apixaban given for
indications other than treatment of DVT and pulmonary embolism is used concurrently with strong CYP3A4 and P-glycoprotein inducers, the patient should be carefully monitored.3,4
Concurrent use of apixaban with other drugs that can affect the clotting process, such as unfractionated heparin, low molecular weight heparins, aspirin, warfarin, and dabigatran, may increase the risk of bleeding.2,3,4 Concurrent use of apixaban and other anticoagulant agents should be avoided, unless switching anticoagulant therapy to or from apixaban.1,3
Prevention of venous thromboembolism following elective knee or hip replacement
Adult oral 2.5mg twice daily, starting 12-24 hours after the procedure, for 10-14 days after knee replacement and 32-38 days after hip replacement1,3
Prevention of stroke and systemic embolism
Adult with at least two of: weight ≤60kg age ≥80 years serum creatinine ≥133µmol/L
oral 2.5mg twice daily1,3
Adult oral 5mg twice daily1,3
Treatment of DVT or pulmonary embolism
Adult oral 10mg twice daily for 7 days then 5mg twice daily1,3
Prevention of recurrent DVT or pulmonary embolism
Adult 2.5mg twice daily after at least 6 months of treatment for DVT or pulmonary embolism 3
Apixaban should be taken at the same time each day.1
Tablets may be crushed and mixed with water, apple juice or applesauce for patients unable to swallow whole tablets, however they must be consumed within four hours.3
Renal impairment
Apixaban should be used with caution in patients with renal impairment. 1 Apixaban is contraindicated in patients with severe renal impairment with creatinine clearance of less than 25mL/minute.3
Apixaban should be used with caution in patients with mild to moderate hepatic impairment. 3
Apixaban is contraindicated in patients with hepatic impairment associated with associated with coagulopathy and an increased risk of bleeding.1,3
Surgery patients
Apixaban should be ceased:3
• For elective procedures or procedures with a high bleeding risk – 48 hours before surgery
• For procedures with a low bleeding risk – 24 hours before surgery.
Pregnancy and breastfeeding
Apixaban is not recommended for use during pregnancy; it has not been established as safe for use.3,5 Alternatives with more safety information, such as heparin or low molecular weight heparins, should be considered.1,5 Apixaban should only be used during pregnancy if the expected benefit is considered to outweigh the potential risk. 3
Apixaban is also not recommended for use while breastfeeding as there is limited evidence on whether it is excreted into breastmilk and the effects on the infant are unknown.1,3,5 Alternatives, such as heparin, low molecular weight heparins, or warfarin, should be considered.1,5
Common adverse effects associated with apixaban include nausea, bleeding, and signs of bleeding, such as anaemia.1
Apixaban may infrequently be associated with thrombocytopenia and abnormal liver function tests.1
Rarely, apixaban may be associated with allergic reactions.1
1. Apixaban. 2023 [cited 2023 Mar 5]. In: Australian Medicines Handbook [Internet]. Adelaide (Australia): Australian Medicines Handbook. Available from: https:// amhonline.amh.net.au.acs.hcn.com.au/chapters/bloodelectrolytes/anticoagulants/factor-xa-inhibitors/apixaban
2. Agrawal A, Kerndt CC, Manna B. Apixaban. 2022 [cited 2023 Mar 5]. In: StatPearls [Internet]. Treasure Island (FL): StatPearls Publishing LLC. Available from: https://www. ncbi.nlm.nih.gov/books/NBK507910
3. Therapeutic Goods Administration. Australian Product Information: Eliquis (apixaban) [Internet]. Woden (Australia): Therapeutic Goods Administration; 2020 [cited 2023 Mar 5]. Available from: https://www.ebs.tga.gov.au/ebs/picmi/ picmirepository.nsf/pdf?OpenAgent&id=CP-2011-PI03072-3&d=20230305172310101
4. Drug interactions: Apixaban. 2023 [cited 2023 Mar 5]. In: Australian Medicines Handbook [Internet]. Adelaide (Australia): Australian Medicines Handbook. Available from: https://amhonline.amh.net.au.acs.hcn.com.au/interactions/ factor-xa-inhibitors-inter#apixaban-inter
5. Apixaban. 2022 [cited 2023 Mar 5]. In: Pregnancy and Breastfeeding Medicines Guide [Internet]. Melbourne (Australia): The Royal Women’s Hospital. Available from: https://thewomenspbmg.org.au/medicines/apixaban
Read this article and complete the quiz to earn 0.5 iFolio hour
Read this article and complete the quiz to earn 0.5 iFolio hour
Brand name: Lyrica, Lyzalon, Neuroccord, Prebalin1
Drug class: antiepileptics1
MECHANISM OF ACTION
Pregabalin binds to presynaptic voltage-gated calcium channels at the alpha-2 delta protein subunit in central nervous system tissues, reducing calcium influx and the release of excitatory neurotransmitters.1,2 This may account for pregabalin’s anticonvulsant and analgesic effects, however its exact mechanism of action is unknown.1
ADMINISTRATION
Pregabalin is administered orally in capsule form.1
INDICATIONS
Indications for pregabalin are:1,3-5
• Treatment of neuropathic pain
• Adjunctive therapy for partial seizures with or without secondary generalisation.
CONTRAINDICATIONS
Pregabalin is contraindicated in patients with a demonstrated hypersensitivity to pregabalin.3-5
INTERACTIONS
Pregabalin has a number of clinically meaningful drug interactions.
Concurrent use of pregabalin with opioids or other central nervous system (CNS) depressants increases the risk of CNS adverse effects, such as respiratory depression and profound sedation.1,3-6 If pregabalin and CNS depressants are used concurrently the patient should be closely monitored, and the dosage of either medication reduced if necessary.1,6
Pregabalin may increase the concentration of clozapine and the risk of toxicity.6 If clozapine and pregabalin are used concurrently the patient should be monitored for adverse effects and the dose of clozapine reduced if necessary.6
The dosage of pregabalin should be individualised to the patient based upon their response and tolerability to treatment.3-5
For the treatment of neuropathic pain, unevenly splitting the daily dose with the larger dose taken in the evening may improve sleep and reduce daytime sedation.1
Renal impairment
Pregabalin should be used with caution in patients with renal impairment.1,3-5 A lower dose should be used for these patients, with the dosage reduced according to estimated creatine clearance (CrCl):1
Adult
oral initially 75mg once daily (at night) for 3-7 days, then 150mg daily in 1 or 2 doses, increased if required after 7 days to 150mg twice daily, and increased if required after a further 7 days to a maximum of 300mg twice daily1
Adult oral initially 75mg twice daily, increased if required after 7 days to 150mg twice daily, and increased if required after a further 7 days to a maximum of 300mg twice daily1
Cardiac conditions
Pregabalin should be used with caution in patients with congestive heart failure.1,3-5
Elderly population
Pregabalin should be used with caution in elderly patients. 1,3-5 Pregabalin is associated with dizziness and drowsiness, which may increase the occurrence of falls in these patients.3,4,5 A lower initial dose and/or slower dose titration may improve tolerability and minimise the risk of adverse effects in elderly patients. 1
History of substance misuse
Pregabalin should be avoided in patients with a history of substance misuse and dependence.1,3-5 Pregabalin is associated with an increased risk of misuse, abuse, and dependence in these patients.1
Patients should be carefully evaluated for a history of substance abuse prior to being prescribed pregabalin and observed for signs of misuse or abuse when taking pregabalin.3-5
Pregnancy and breastfeeding
Pregabalin is not recommended for use during pregnancy.3-5,7 Use of antiepileptic drugs during pregnancy is associated with an increased incidence of congenital malformations.8 Recognising that uncontrolled epilepsy may compromise maternal health and pregnancy outcomes, an individual assessment of the risks and benefits of treatment to both the mother and fetus should be made.3-5,7,8 Pregabalin should only be used if the expected benefit is considered to outweigh the potential risk.35 Specialist advice should be sought before prescribing pregabalin for use during pregnancy. 1
Pregabalin is also not recommended for use while breastfeeding as the effects on the infant are unknown.3-5 As pregabalin is excreted into breastmilk, if it is used while breastfeeding the infant should be monitored for adverse effects, such as irritability, excessive drowsiness, and poor feeding.7
The most common adverse effects associated with pregabalin are dizziness and somnolence.3-5 Other common adverse effects include confusion, depression, irritability, euphoria, amnesia, insomnia, fatigue, vertigo, impaired balance, visual disturbances, constipation, weight gain, muscle cramp, arthralgia, dysarthria, tremor, ataxia, hypoaesthesia, dry mouth, and peripheral oedema.1
Pregabalin is infrequently associated with cognitive impairment, agitation, hallucinations, hypotension, hypertension, tachycardia, firstdegree heart block, thrombocytopenia, fainting, myoclonus, hyperaesthesia, myalgia, urinary incontinence, dysuria, increased creatine kinase, sexual dysfunction, neutropenia, excessive salivation, rash, flushing, and sweating.1
Rarely pregabalin is associated with dysphagia, pancreatitis, delirium, oliguria, respiratory depression, heart failure, rhabdomyolysis, renal failure, hypersensitivity reactions such as anaphylaxis and angioedema, and severe skin reactions, such as Steven-Johnson syndrome.1 Suddenly stopping the use of pregabalin can cause withdrawal symptoms such as nausea, diarrhoea, anxiety, insomnia, and sweating. 1
1. Pregabalin. 2023 [cited 2023 Jan 22]. In: Australian Medicines Handbook [Internet]. Adelaide (Australia): Australian Medicines Handbook. Available from: https:// amhonline.amh.net.au/chapters/neurological-drugs/ antiepileptics/gabapentinoids/pregabalin
2. Cross AL, Viswanath O, Sherman AI. Pregabalin. 2022 [cited 2023 Jan 22]. In: StatPearls [Internet]. Treasure Island (FL): StatPearls Publishing LLC. Available from: https://www.ncbi.nlm.nih.gov/books/NBK470341
3. Therapeutic Goods Administration. Australian Product Information: Lyrica [Internet]. Woden (Australia): TGA; 2022 [cited 2023 Jan 22]. Available from: https:// www.ebs.tga.gov.au/ebs/picmi/picmirepository.nsf/ pdf?OpenAgent&id=CP-2010-PI-04219-3
4. Therapeutic Goods Administration. Australian Product Information: Lyzalon [Internet]. Woden (Australia): TGA; 2021 [cited 2023 Jan 22]. Available from: https:// www.ebs.tga.gov.au/ebs/picmi/picmirepository.nsf/ pdf?OpenAgent&id=CP-2016-PI-01524-1
5. Therapeutic Goods Administration. Australian Product Information: Neuroccord [Internet]. Woden (Australia): TGA; 2021 [cited 2023 Jan 22]. Available from: https:// www.ebs.tga.gov.au/ebs/picmi/picmirepository.nsf/ pdf?OpenAgent&id=CP-2017-PI-02303-1
6. Drug interactions: Gabapentinoids. 2023 [cited 2023 Jan 22]. In: Australian Medicines Handbook [Internet]. Adelaide (Australia): Australian Medicines Handbook. Available from: https://amhonline.amh.net.au/ interactions/gabapentinoids-inter
7. Pregabalin. 2021 [cited 2023 Jan 22]. In: Pregnancy and Breastfeeding Medicines Guide [Internet]. Melbourne (Australia): The Royal Women’s Hospital. Available from: https://thewomenspbmg.org.au/ medicines/pregabalin
8. Antiepileptics: Epilepsy. 2023 [cited 2023 Jan 22]. In: Australian Medicines Handbook [Internet]. Adelaide (Australia): Australian Medicines Handbook. Available from: https://amhonline.amh.net.au/chapters/ neurological-drugs/antiepileptics/epilepsy
Tuesday, June 04 6pm
June 06 12pm


Office + Zoom Tuesday, June 11 6pm
Court
Office + Zoom Thursday, June 13 12pm
Tuesday, June 18 6pm
Thursday, June 20 12pm
Tuesday, June 25 6pm
June 27
Tuesday, July 16 6pm
Court ANF Office + Zoom
Media
Office + Zoom
Office + Zoom Thursday, July 18 12pm
Tueday, July 23 6pm
Thursday, July 25 12pm
The ANF offers informative talks on topics relevant to contemporary nursing and midwifery, all for free.
Places are available on a range of topics:
Coroners Court: Learn more about coroners' investigations including discussions on the role of the coroner, the inquest process, evidence gathering, being a witness, making statements and other legal considerations surrounding coroners' reports.
Documentation: A handy refresher on the importance of proper documentation, best practices for record-keeping, legal requirements for documentation and how to maintain accurate and comprehensive records.
Social Media: Take part in discussions around potential legal issues that can arise from its use including privacy concerns, defamation, intellectual property infringement, professional boundaries and ethical considerations when using all types of online media platforms.
ANF Office + Zoom
Office + Zoom
Discrimination: This talk covers the legal framework surrounding discrimination, including laws, regulations and case precedents, with reference to the various forms of discrimination, such as gender, race, age, or disability and provide guidance on how to prevent and address such issues in professional settings.
Defamation: Defamation involves making false statements that harm someone's reputation. We explain the elements of a defamation claim, how to minimize the risk of defamation in the context of the workplace, defences against defamation and the potential consequences of defamatory statements on your registration and your wallet.
Workers Compensation: This session covers the essentials that all members must know about the Workers’ Compensation process and how to make it work for you rather than your employer if you are injured at work.
Resolve workplace issues: This important information is useful for all members, and it covers the process of resolving issues at your workplace.